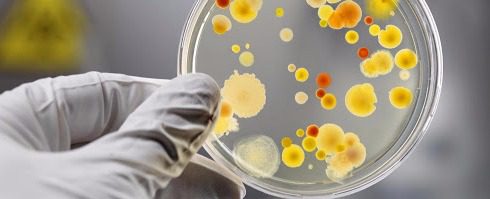
КИШКОВІ ІНФЕКЦІЇ

Актуальна інформація про інфекції та щеплення тепер у зручному Телеграм-боті!
Актуальна інформація про інфекції та щеплення тепер у зручному Телеграм-боті! Чат-бот з вакцинації розробила громадська спілка “Коаліція за вакцинацію” в рамках проєкту USAID “Розбудова стійкої системи громадського здоров’я“, аби вакцинуватися українцям стало ще легше та зручніше. Аби скористатися сервісом, просто відскануйте qr-код, введіть у Телеграм-пошук ім’я @UaVaxBot чи перейдіть за посиланням https://t.me/UaVaxBot З чат-боту ви дізнаєтесь про таке: інфекційні ризики для українців та захист від інфекцій; відповіді на поширені запитання про вакцини та щеплення; офіційні ресурси з інформацією про інфекції та вакцинацію. Уже зараз UaVaxBot може розрахувати графік щеплень за датою вашого народження! А в майбутньому із його допомогою можна буде записатись на вакцинацію або зв’язатись зі своїм лікарем. Приєднуйтесь, тестуйте бот на зручність і залишайте свої відгуки! Перейдіть за посиланням https://t.me/UaVaxBot (або відскануйте qr-код чи введіть у Телеграм-пошук ім’я…